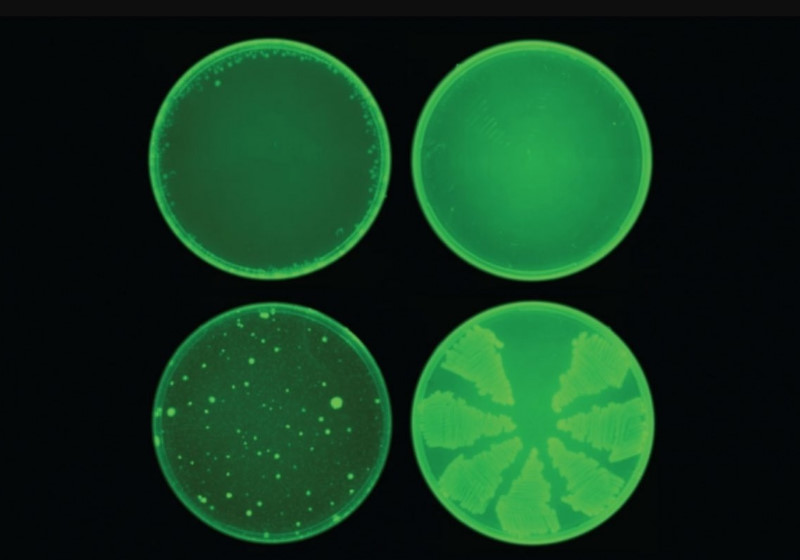
A halicina (acima) impediu o desenvolvimento de resistência a antibióticos em E. coli

Criado nos EUA antibiótico poderoso contra superbactérias
Cientistas do MIT – Instituto de Tecnnologia de Massachusetts, nos EUA, criaram um antibiótico poderoso que mata superbactérias – bactérias resistentes a medicamentos – graças à inteligência artificial – IA.
A descoberta importante foi publicada no periódico científico Cell. Os pesquisadores treinaram um algoritmo para identificar os tipos de moléculas que matam bactérias.
“Nossa abordagem revelou uma molécula incrível, que é sem dúvida um dos antibióticos mais poderosos já descobertos”, disse James Collins, um dos autores do estudo, em comunicado.
A molécula foi batizada de halicina, em homenagem a Hal, a IA do filme 2001: Uma Odisseia no Espaço, de Stanley Kubrick.
Originalmente desenvolvida para tratar diabetes, ela se mostrou capaz de tratar inúmeras infecções.
Como
Eles forneceram ao programa informações sobre as características atômicas e moleculares de quase 2500 medicamentos e compostos naturais, além de dados sobre quanto cada substância bloqueia o crescimento da bactéria Escherichia coli.
O algoritmo aprendeu quais características moleculares produziam bons antibióticos e os cientistas o colocaram para trabalhar em uma biblioteca com mais de 6 mil compostos que estão sendo investigados como potenciais medicamentos.
A tecnologia se concentrou em encontrar compostos eficazes, mas diferentes dos antibióticos já existentes – o que garantiria o efeito contra bactérias resistentes.
Antibiótico poderoso
Demorou apenas algumas horas para o algoritmo avaliar os compostos e apresentar alguns antibióticos promissores, como a halicina.
“Queríamos desenvolver uma plataforma que nos permitisse aproveitar o poder da inteligência artificial para inaugurar uma nova era de descoberta de antibióticos”, disse.
Testes
Testes em culturas bacterianas mostraram que a halicina pode matar a Mycobacterium tuberculosis, que causa tuberculose, e as cepas de Enterobacteriaceae resistentes aos carbapenêmicos, um grupo de antibióticos considerados o último recurso para tratar infecções provocadas por esse microrganismo.
Além disso, testes em ratos provaram a eficácia da substância contra outras duas espécies de organismos multirresistentes, a Clostridium difficile e a Acinetobacter baumannii.
“Esse trabalho inovador significa uma mudança de paradigma na descoberta de antibióticos e, de fato, na descoberta de medicamentos em geral”, afirmou Roy Kishony, professor do Technion – Instituto de Tecnologia de Israel.
“Essa abordagem permitirá o uso de “machine learning” em todos os estágios do desenvolvimento de antibióticos.”
Com informações do GNN
Espalhe notícia boa nas suas redes sociais. Siga o SNB no:

Tratamento para linfoma de Hodgkin é aprovado pela Anvisa: reduz risco de morte em 60%
Spray nasal contra demência reverte envelhecimento do cérebro em ratos; dizem cientistas
Nova tecnologia detecta câncer de pâncreas 3 anos antes do diagnóstico
Anvisa autoriza o uso do Mounjaro para diabetes tipo 2 em crianças
Anvisa autoriza produção da vacina brasileira contra chikungunya: Butantan
Cozinhar pode reduzir risco de demência em 30% em idosos, revela novo estudo
Veja a MP lançada para segurar preço da gasolina; já está valendo
Paulinho da Costa recebe estrela na Calçada da Fama com bandeira do Brasil: capa da Rolling Stone
Motoboy se emociona ao ganhar marmita do dono de restaurante: gentileza
Vini Jr. abre escritório de advocacia para defender vítimas de racismo no Brasil; veja como será
Sobe para 200 milhões prêmio da Mega-Sena 30 anos; veja quando será o sorteio
Jovem que nasceu prematura hoje trabalha no hospital que salvou a vida dela